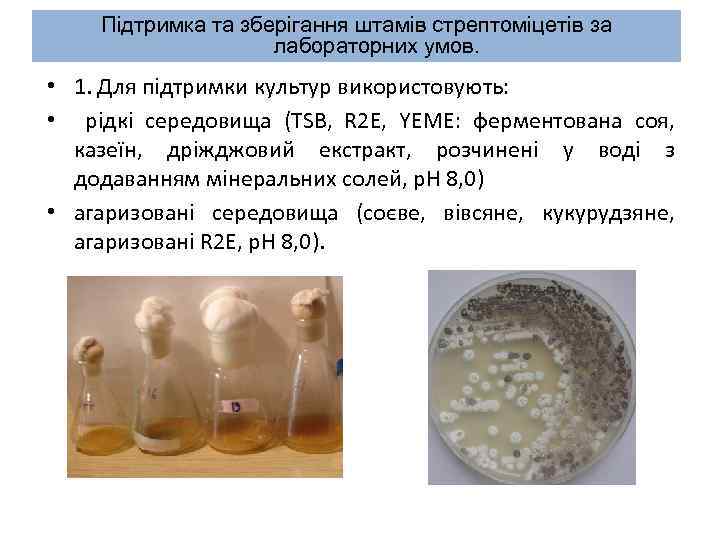
Підтримка та зберігання штамів стрептоміцетів за лабораторних умов. • 1. Для підтримки культур використовують:

MOG-4.pptx
- Количество слайдов: 33

Streptomyces coelicolor – модельний об'єкт генетики

План лекції q q q q Streptomyces coelicolor – представник актиноміцетів. Цикл розвитку Streptomyces coelicolor. Генетичні особливості Streptomyces coelicolor (хромосома, плазміди, мутантні штами) та їх використання у лабораторних дослідженнях. Регуляція біосинтезу актинородину у Streptomyces coelicolor. Труднощі роботи з актиноміцетами. Стрептоміцети, які досліджують у лабораторії при кафедрі. Способи підтримки штамів за лабораторних умов. Колекції штамів актиноміцетів.

Література q Федоренко, В. О. Великий практикум з генетики, генетичної інженерії та аналітичної біотехнології мікроорганізмів / В. О. Федоренко, Б. О. Осташ, М. В. Гончар, Ю. В. Ребець; Львівський нац. університет імені Івана Франка. – Л. : Видавничий центр ЛНУ імені Івана Франка, 2007. – 279 с. q Ленгелер Й. Современная микробиология. Прокариоты: 2 -й том. Й. Ленгелер, Г. Древс, Г. Шлегель. – М. : Мир, 2005. – 496 с. q Kieser T. Practical Streptomyces genetics / Kieser T. , Bibb M. J. , Buttner M. J. , Chater K. F. and Hopwood D. A. – Norwich, England: John Innes Foundation, 2000. – 634 p.

Домен Bacteria (Бактерії) Тип Actinobacteria (Актинобактерії) Клас Actinobacteria (Актинобактерії) Порядок Actinomycetales (Актиноміцети) Родина Streptomycetaceae Рід Streptomyces (Стрептоміцети) Вид Streptomyces coelicolor

Актиноміцети –грампозитивні бактерії з високим GCскладом ДНК. ü GC-склад ДНК організму (вміст гуанінових і цитозинових залишків у ДНК) – таксономічна ознака бактерій. q Актиноміцети – збудники хвороб людини (прокази, Mycobacterium leprae; туберкульозу, Mycobacterium tuberculosis; дифтерії, Corynebacterium diphtheriae). q Актиноміцети – джерело отримання біологічно активних речовин, зокрема : o антибіотиків – Saccharopolyspora erythraea – еритроміцин, Amycolatopsis mediterranei – рифампіцин; o імуносупресантів – Streptomyces hygroscopicus - рапаміцин.

Актиноміцети, виділені з рослин (ендофіти). Продукують рослинні гормони (ауксини), антибіотики.

Актиноміцети, виділені з ґрунту. Продукують низку біологічно активних речовин та ферментів. Розкладають органічні рештки (вуглеводи, білки, нуклеїнові кислоти), беруть участь у формуванні гумусу. Актиноміцети, виділені з океанічних вод. Salinispora tropica, синтезує протипухлинний антибіотик – саліноспорамід А

Колонія S. coelicolor – сукупність морфологічно неоднорідних клітин Поперечний переріз через колонію S. coelicolor Повітряний міцелій із спорами Синтез актинородину Вегетативний міцелій Chater K F Phil. Trans. R. Soc. B 2006; 361: 761 -768

Чотири стадії розвитку колонії S. lividans a) Вегетативний міцелій b) Повітряний міцелій с), d) Утворення спор

Цикл розвитку Streptomyces coelicolor за лабораторних умов Екзоспора 10 год ланцюжки спор 30 год Проростання спори 48 -72 год bld. A, B, C, D; sap. B 48 год whi. I, H, A, B, G субстратний (вегетативний) міцелій Формування повітряного міцелію, синтез антибіотика • Гіфи – мультинуклеоїдні; • 1 спора – 1 нуклеоїд. Спряженість процесу утворення перегородок, реплікації і конденсації ДНК у спорулюючій гіфі контролюється генами whi. I, H, A, B, G. üСпори найчастіше використовують для отримання генетично однорідної

Координація морфологічної диференціації та синтезу антибіотика у Streptomyces coelicolor. Колонія дикого типу Chater K F Phil. Trans. R. Soc. B 2006; 361: 761 -768 Мутант з інактивованим геном bld. A

Координація морфологічної диференціації та синтезу антибіотика у Streptomyces coelicolor. aсt II – ORF IV Синтнез актинородину bld. A adp. A утворення повітряного міцелію Øbld. A – ген лейцинової транспортної РНК (т-РНК leu), яка розпізнає кодон UUA у матричній РНК. Наявність т-РНК leu необхідна для трансляції молекул м-РНК, які містять кодон UUA. ØУ ДНК-послідовності кодону UUA відповідає ТТА-кодон. Кодон ТТА є рідкісний у геномі стрептоміцетів, як правило, наявний у генах, що не контролюють життєво необхідні процеси. ØГен adp. A містить кодон ТТА і кодує регуляторний білок Adp. A, який є ключовим Chater K F Phil. Trans. R. Soc. B 2006; 361: 761 -768 фактором для ініціації утворення повітряного міцелію. ØГен aсt II –ORF IV – активатор кластера генів біосинтезу актинородину, містить TTA-кодон.

Streptomyces coelicolor - генетична модель üStreptomyces coelicolor - модель дослідження генетики клітинної диференціації актиноміцетів.

Геном Streptomyces coelicolor: хромосома Хромосома Streptomyces coelicolor: q. Лінійна, на кінцях ковалентно зв’язана з термінальними білками; q. Розмір – 8667507 п. н. ; q. Містить 7825 генів, що кодують білки. q. Складається з корової (темно синя) і субтермінальних (голубі) частин. q. Термінальні частини можуть втрачатися. q. Всі життєво важливі гени містяться у коровій частині. Ori. C

Streptomyces coelicolor - генетична модель üStreptomyces coelicolor – модель дослідження генетики клітинної диференціації актиноміцетів. üStreptomyces coelicolor – модель структури геному актиноміцет.

Геном Streptomyces coelicolor: плазміди Плазміди Streptomyces coelicolor: q SCP 1 (350 т. п. н. ) – лінійна, містить гени біосинтезу метиленоміцину (як виняток). q SCP 2 (31 т. п. н. ) – кільцева; структурні елементи використовують для конструювання векторів. q. SLP 1 (17 т. п. н. ) – як правило, інтегративна у хромосому. q. Більшість плазмід стрептоміцетів не містять гени стійкості до антибіотиків чи гени біосинтезу антибіотиків.

Помірні сайтспецифічні бактеріофаги S. coelicolor qф. С 31 – специфічно інтегрується у хромосому завдяки активності гена int, що кодує білок інтегразу. Інтеграза розпізнає сайт att. P у власній (фаговій) ДНК і сайт у хромосомній ДНК att. В (90 т. п. н. зліва від ori. C). qф. BT 1 – інтегрується в інший сайт хромосоми справа від ori. C. q. Використовуються як джерело фрагментів ДНК, що містять ген інтегрази та att. P для конструювання інтегративних векторів і штучних хромосом. Такі конструкції використовуються для гетерологічної експресії генів. q. Наприклад, для того щоб з’ясувати функцію гена (генів), ДНК цього гена клонують у вектор, який у свою чергу інтегрується у хромосому гетерологічного штаму. Спостерігають за зміною фенотипу (стійкість до антибіотика).

Вектори, які використовують у генетиці стрептоміцет 1. Вектори, які можуть реплікуватися (підтримуватись) лише у стрептоміцетних клітинах: p. IJ 101 2. Вектори, які здатні до реплікації як у клітинах E. coli так і у стрептоміцетах – човникові вектори: qp. KC 1218 – низькокопійний вектор (гетерологічна експресія генів, що кодують токсичні продукти). q p. SET 152 – інтегративний вектор. qp. KC 1139 – температурочутливий вектор. ori. SCP 2*, orip. UC 18 - ділянки ініціації реплікації у клітинах стрептоміцет та E. coli, відповідно. Int ф. С 31 – ген інтегрази. ori. T RK 2 – послідовність, необхідна для конюгативного перенесення плазміди

Streptomyces coelicolor - генетична модель üStreptomyces coelicolor – модель дослідження генетики клітинної диференціації актиноміцетів. üStreptomyces coelicolor – модель структури геному актиноміцет. üStreptomyces coelicolor – модель генно-інженерних досліджень стрептоміцетів.

Вторинний метаболізм q Вторинний метаболізм – це сукупність біохімічних реакцій, у яких первинні метаболіти перетворюються у невеликі молекули (до 2 к. Да) – вторинні метаболіти - які не є важливими для виживання організму за неселективних умов. q Стрептоміцети синтезують більшість відомих активних вторинних метаболітів, серед яких антибіотики, імуносупресанти. q У стрептоміцетних штамах дикого типу, як правило, рівень синтезу антибіотика низький. q Високий рівень синтезу – одна з основних вимог для комерційного виробництва антибіотика. q Маніпуляція генами, що контролюють біосинтез антибіотика - один із способів підвищити синтез або отримати аналоги антибіотика.

S. сoelicolor – продуцент актинородину. Синтез актинородину контролюється 23 генами, які згруповані в кластер (actкластер). Активність генів біосинтезу актинородину строго контролюється. Активатором біосинтезу актинородину є шлях-специфічний регулятор Асt. IIORF 4. Поява активатора контролюється низкою інших регуляторів. Afs. S Afs. R Adp. A Pho. P Sco 6808 ? Sar. A Cpr. B Abs. B t. RNAUUA Pi Rap. A 2 Rap. A 1 Act. R SAM Sco 0877 Das. R Nsd. A Rok 7 B 7 Afs. K Nsd. B Act, I, II act. R act. A Scb. A Wbl. A Bld. D Abs. A 2 Abs. A 1 Atr. A act. II-ORF 4 Актинородин act. VI-ORFA Glc. NAc Aba. A Scb. R 2 Sco 7173 Act. VI-ORFA ? Act. II-ORF 4 Sco 0608 ?

Штами S. coelicolor, які використовують у генетиці. A 3(2) – штам дикого типу. M 145 – похідний штаму A 3(2) - прототрофний штам, який використали для секвенування геному, не містить плазмід і генетичних маркерів, синтезує актинородин, ундецилпродегіозин тощо. CH 999 – pro A 1, arg. A 1, red. E 60, Δact: : erm. E SCP 1 - SCP 2 - – відсутній синтез кольорових сполук, ауксотроф за проліном та аргініном. M 512 – Δact: : erm. E , Δred. D, похідний М 145, не синтезує кольорових сполук. М 1152 – Δact, Δred, rpo. B - похідний М 145, містить делеції трьох кластерів генів вторинних метаболітів та точкову мутацію у гені РНК-полімерази. М 521 – Δact. II-ORF 4, мутантний штам з інактивованим шлях-специфічним регулятором синтезу актинородину.

Дослідження стрептоміцетів при кафедрі генетики і біотехнології Streptomyces cyanogenus S 136 продуцент ландоміцину А (протипухлинна активність) lan-кластер (La. A) E F A B C D L M O P G H Q R S T U V GT 2 X GT 1 K J Z 1 GT 3 Z 2 Z 3 GT 4 Z 5 Z 6 I

Дослідження стрептоміцетів при кафедрі генетики і біотехнології q. Дослідження регуляції біосинтезу антибіотиків (сіоміцину, моеноміцину, тейкопланіну, ландоміцину). q. Пошук нових біологічно активних сполук актиноміцетного походження. Моеноміцин (антибактерійна активність) Сіоміцин (протималярійна, протипухлинна активність)

Streptomyces coelicolor - генетична модель üStreptomyces coelicolor – модель дослідження генетики клітинної диференціації актиноміцетів. üStreptomyces coelicolor – модель структури геному актиноміцет. üStreptomyces coelicolor – модель генноінженерних досліджень стрептоміцетів. üStreptomyces coelicolor – модель дослідження генетичного контролю синтезу антибіотиків.

Стрептоміцети – модельні об’єкти генетики • Streptomyces coelicolor – модельний об’єкт вивчення фізіології, біохімії, генетики стрептоміцетів. • Streptomyces albus – модель експресії чужорідних генів, дослідження генів температурного шоку. • Streptomyces lividans – модель для дослідження структури та нестабільності геному, гетерологічної експресії генів, мікроскопії циклу розвитку стрептоміцет. • Streptomyces glaucescens – модель дослідження нестабільності геному стрептоміцет, біосинтезу жирних кислот. • Streptomyces clavuligerus – модель вивчення біосинтезу клавуланової кислоти.

Труднощі роботи з актиноміцетами. • Відносно довгий час генерації. • Мають природну стійкість до низки антибіотиків. • Нестабільність геному – часто втрачають значну частину хромосоми. • Клітини несприятливі для конструювання рекомбінантних молекул ДНК. • Гетероморфність колоній. Полінуклеоїдний міцелій. • Міцеліальний ріст.
Підтримка та зберігання штамів стрептоміцетів за лабораторних умов. • 1. Для підтримки культур використовують: • рідкі середовища (TSB, R 2 E, YEME: ферментована соя, казеїн, дріжджовий екстракт, розчинені у воді з додаванням мінеральних солей, p. H 8, 0) • агаризовані середовища (соєве, вівсяне, кукурудзяне, агаризовані R 2 E, p. H 8, 0).

Зберішання штамів стрептоміцетів • При 4°С – на твердому середовищі – 2 (неспорулюючі) - 8 тижні (спорулюючі). • При -20°С (краще при -80°С )– гліцеринові культури спор або міцелію неспорулюючих штамів – кілька років. • Ліофілізовані культури (дегідратовані) – кілька десятків років.

Колекції штамів актиноміцетів q Culture Collection of Switzerland (CCOS) q ARS Culture Collection (NRRL, США) – 95, 000 штамів мікроорганізмів, зокрема актиноміцетів q Culture Collection of Soil Actinomycetes (Чехія) – 1073 штами Streptomyces q American Type Culture Collection (ATCC)

Дякую за увагу

Mutants in the bld. A and bld. H genes behave similarly in a cascade of extracellular signals that leads to aerial growth. Chater K F Phil. Trans. R. Soc. B 2006; 361: 761 -768 © 2006 by The Royal Society

Role of bld. A in autoregulatory circuits for antibiotic production. Chater K F Phil. Trans. R. Soc. B 2006; 361: 761 -768 © 2006 by The Royal Society
MOG-4.pptx